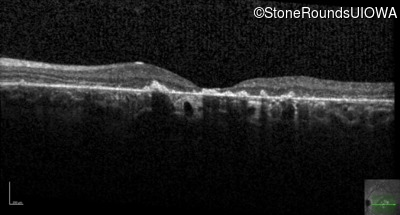
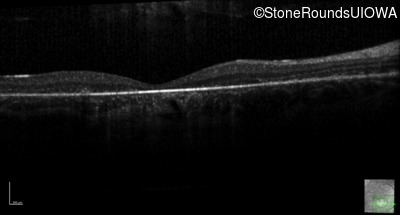
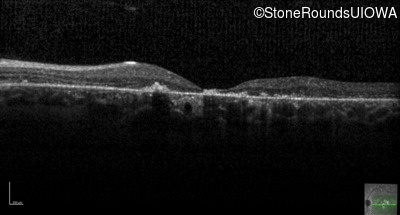
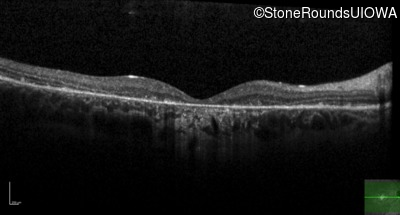
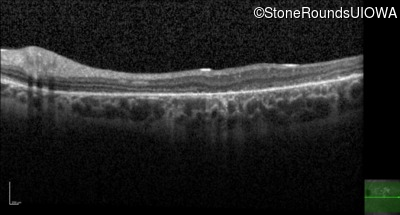

Case
SR446
Student Mode
AR Stargardt Disease (IIA)
Female
Female
Hidden
SR446
Student Mode
AR Stargardt Disease (IIA)
Female
Female
History
This 26 year old woman first had difficulty seeing the blackboard at age 8. Her father lost his commercial driver's license at age 50 secondary to a macular dystrophy.
| Age at visit: 26 years |
| Age at visit: 27 years |
Diagnosis & molecular findings
| Disease | Gene | Allele 1 variant(s) | Allele 2 variant(s) | Inheritance mode |
|---|---|---|---|---|
| AR Stargardt Disease | ABCA4 | Phe418Ser TTT>TCT | Pro1380Leu CCG>CTG | AR |
Disease:
Gene:
Allele 1:
Phe418Ser TTT>TCT
Allele 2:
Pro1380Leu CCG>CTG
Inheritance:
AR